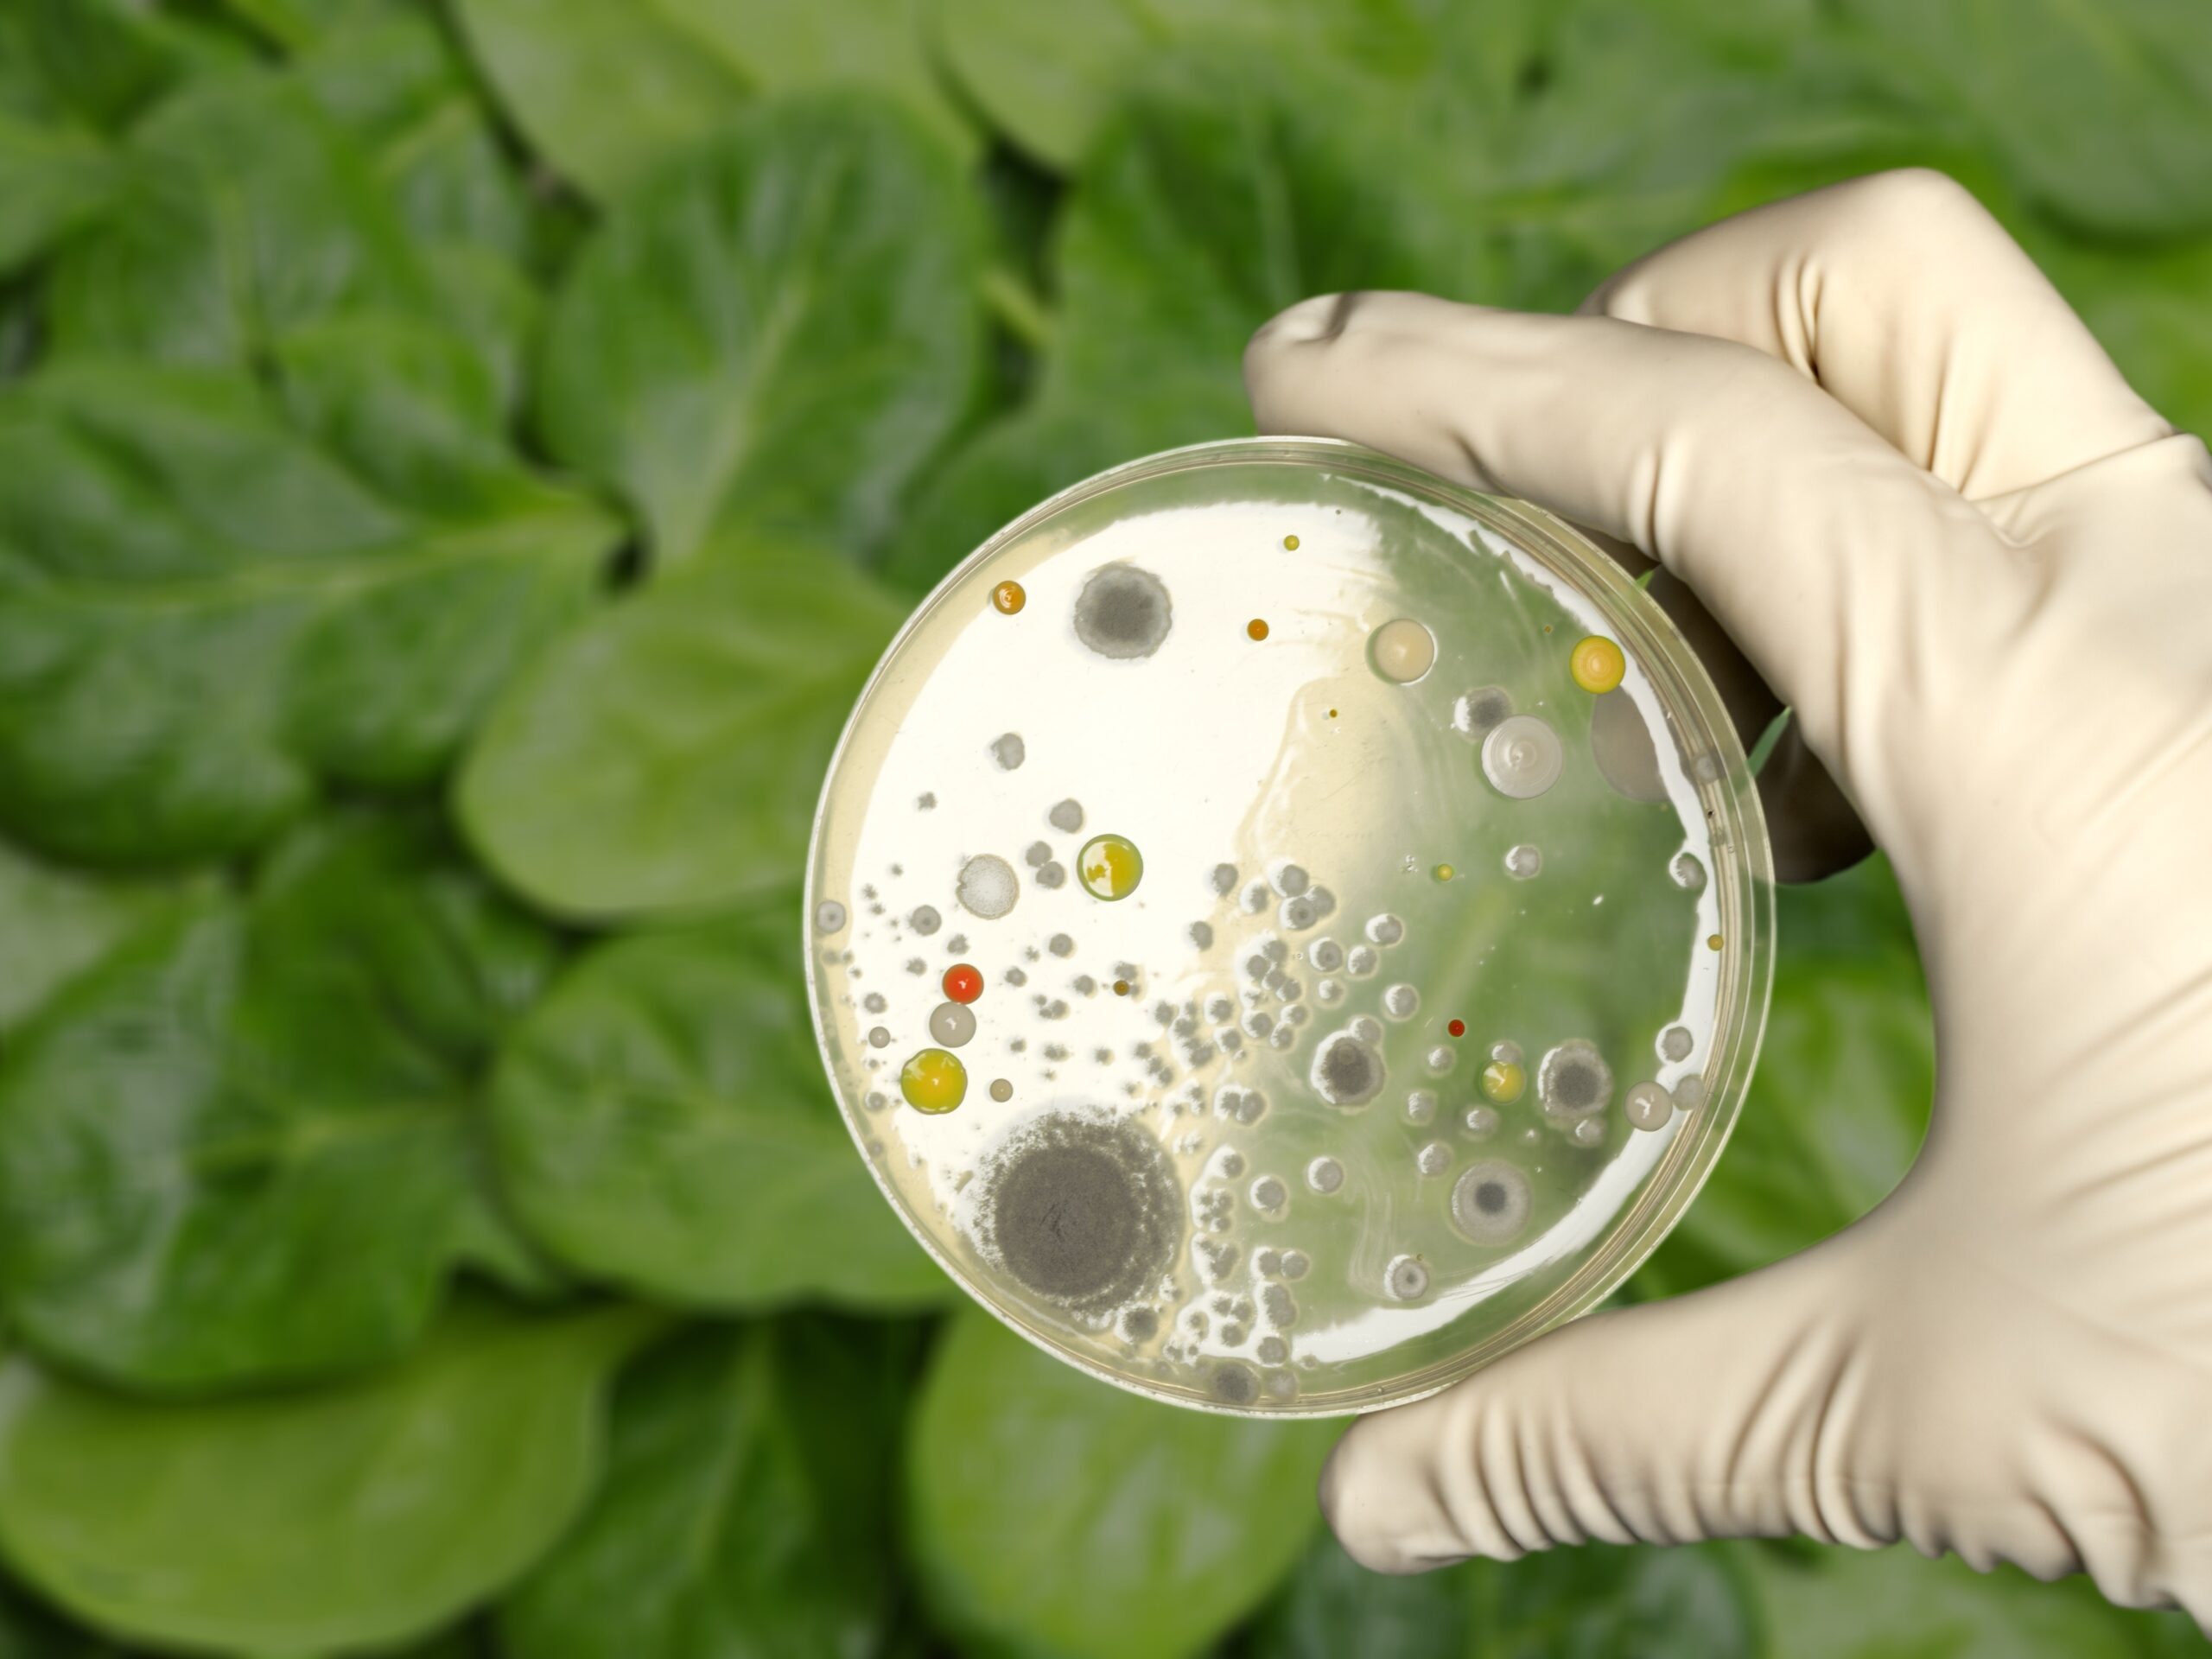

Imagine sitting down at a beloved local steakhouse, ready to enjoy a carefully prepared meal, only to learn later that the food you ate was deliberately contaminated by a kitchen worker. This unsettling reality unfolded at the Hereford House in Leawood, Kansas, where Jace Hanson, a 22-year-old kitchen employee, engaged in a shocking betrayal of public trust and health. Between late March and April 2024, Hanson reportedly filmed himself contaminating food in grotesque ways — urinating in sauces, rubbing food on his genitals, and stomping on meals — then posted these videos online under the username “Vandalizer.” The fallout was swift and severe, culminating in Hanson’s sentencing to more than 11 years in prison in October 2025.
The Betrayal Behind the Kitchen Door
Jace Hanson’s actions were not just a breach of food safety; they were a direct assault on the trust customers place in restaurants. The Hereford House, a local steakhouse chain serving the Kansas City metro area since 1957, suddenly found itself at the center of a public health nightmare. Hanson, who had been in training as a cook during his brief employment, reportedly admitted to contaminating food about 20 times over the course of a month. His videos showed him urinating in Au Jus sauce and pickle jars, pressing food against his genitals and buttocks, and even stomping on meals before they were served to unsuspecting patrons, as reported by Law & Crime.
The videos surfaced on social media, sparking outrage and a swift investigation. An anonymous tip reportedly led the FBI to the footage, which they traced back to Hanson using IP addresses and other digital evidence.
The Investigation and Its Shocking Discoveries
The investigation revealed more than just food tampering. When authorities searched Hanson’s devices, they reportedly uncovered disturbing child sexual abuse material and messages expressing his desire to commit sexual violence against children. Leawood Police Detective Jack Bond described the content as “the most brutal and violent child sexual-abuse material that I have ever seen,” — so graphic that he had to take breaks while reviewing it, as reported by PEOPLE.
These findings added a grim layer to an already disturbing case. Hanson’s possession of such material led to 10 additional felony counts of child sexual exploitation, alongside 22 counts of criminal threat related to the food contamination, and one count of criminal damage over $25,000.
The Courtroom Drama and Sentence
On October 9, 2025, Hanson faced a Johnson County judge who handed down the maximum sentence allowed under Kansas law: 11 years and 4 months in prison. The judge expressed deep concern about Hanson’s “future danger” to the community upon release, emphasizing the severity of his crimes and the evidence presented, as reported by Law & Crime.
During the sentencing hearing, Hanson reportedly apologized to his family, coworkers, and the patrons of Hereford House, expressing regret and a desire to change, saying “I would take it all back if I could,” as reported by Law & Crime. However, the judge and prosecutors made it clear that the damage Hanson caused was profound and far-reaching. The assistant district attorney noted that Hanson’s actions “singlehandedly” led to the closure of the Hereford House’s Leawood location, a significant blow to the local business and community, as reported by Law & Crime.
The Fallout for Hereford House and Its Customers
The Hereford House’s Leawood location closed in August 2024, just months after Hanson’s arrest, citing financial strain caused by the scandal. The public’s loss of trust and the barrage of nearly 400 food-poisoning complaints received by local police during the investigation contributed heavily to this outcome. At least 13 civil lawsuits were reportedly filed against the restaurant, reflecting the widespread impact of Hanson’s actions on customers and employees alike.
The scandal serves as a stark reminder of the vulnerabilities in food service and the critical importance of trust between businesses and their patrons. For many, dining out is a routine pleasure, but Hanson’s case reveals how that trust can be shattered in the most disturbing ways.
Understanding the Motive and Broader Implications
Hanson told investigators that he contaminated food partly because men he met online requested the videos, and partly because he disliked his job, as reported by Johnson County Post. This disturbing admission points to a complex web of personal deviance and external influence. While the food contamination was a public health violation, the discovery of child sexual abuse material on Hanson’s devices highlights a separate but equally serious criminal dimension.
The case underscores the challenges law enforcement faces in addressing crimes that cross multiple domains — from public safety to child protection. It also raises questions about workplace oversight and the mechanisms in place to prevent such breaches of trust.
References: Restaurant Worker Filmed Himself Urinating on Food – What Cops Found on His Phone Was Even Worse | Judge upbraids man who contaminated steak restaurant’s food | KC man who contaminated food at Hereford House gets 11 years







